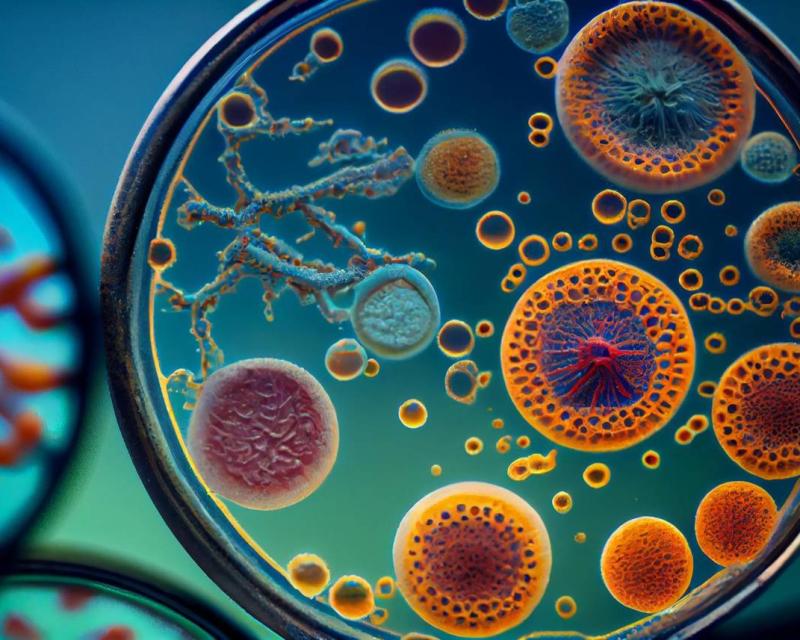
Bassanonet.it Oggi emme... domani no

Ultimora
27 Jan 2026 15:48
Sabato via al Carnevale di Venezia, nel segno delle Olimpiadi
27 Jan 2026 15:09
Università di Padova, collocata una pietra d'inciampo per Leopold Goetz
27 Jan 2026 12:59
Giornata Memoria: a Verona imbrattato monumento Shoah
27 Jan 2026 12:50
Celebrata al Ghetto di Venezia la Giornata della Memoria
27 Jan 2026 12:17
Bambine di 4 e 5 anni travolte su strisce pedonali, non sono gravi
27 Jan 2026 16:30
Fondi per gli sfollati di Niscemi, fino a 900 euro mensili a famiglia
27 Jan 2026 16:36
Rimasto per ore senza barella a Senigallia, morto il paziente oncologico
27 Jan 2026 16:18
Femminicidio di Federica Torzullo, accertamenti sulla scatola nera dell'auto di Carlomagno. I genito
27 Jan 2026 16:14
Dialetto addio, in famiglia si parla solo l'italiano
Redazione

Paolo Massimiliano Paterna
Giornalista Bassanonet.itGiornalista, Illustratore, fumettista, pittore, ha esposto in Italia ed Austria. Diploma triennale della Scuola del Fumetto. Diploma accademico di Secondo livello in Arti Visive dell'Accademia di Belle Arti, equipollente alla Laurea Magistrale in Storia dell'Arte.
Tutti gli articoli
Libri
Qualcuno era democristiano
La fine dell’unità politica dei cattolici tra Prima e Seconda Repubblica
Contaminazioni
Deus est machina
“Non ha senso bruciare foreste per alimentare l’intelligenza artificiale che traccia la...
Contaminazioni
Oggi emme... domani no
Quando le piante ottenute con le Nuove Tecniche Genomiche possono essere considerate equivalenti...
Contaminazioni
Quanto conta il contante?
“Nessuno ha bisogno dell'euro digitale"
Contaminazioni
Sterility sharing
Impotenti davanti ad uno smartphone: sebbene l'uso del cellulare sia considerato sicuro, si è poco...
Contaminazioni
Io vi troverò
Armi biologiche etniche, uccidere tutti o soltanto alcuni?
Contaminazioni
European Media Freedom Act
La libertà di fare il giornalista nell’Unione Europea e la sicurezza nazionale
Contaminazioni
Italia per la pace?
Tre quesiti per il referendum abrogativo
Contaminazioni
Lo stomaco di ferro della Commissione europea
Gli alimenti tradizionali sono un sottoinsieme dei nuovi alimenti
Contaminazioni
Invisibili, il documentario invisibile
Il documentario “Invisibili”, diretto da Paolo Cassina denuncia effetti avversi alla...
Contaminazioni
Covid Free
Secondo il Dipartimento dell'Energia e l’FBI la fuga dal laboratorio è l'origine più probabile...
Contaminazioni
Le Finestre spalancate di Overton
Joseph P. Overton elabora una complessa strategia di comunicazione per l’introduzione e la...
Contaminazioni
Otto miliardi di cosa?
Dalle statistiche dell’ONU sull’incremento della popolazione mondiale alle sue conseguenze...
Contaminazioni
Reporters Sans Frontières e la Libertà di stampa in Italia, aspettando il 2023
Sebbene l’Italia sia scesa al 58° posto nella classifica mondiale, il report parla di un Paese...
Il 27 gennaio
- 27-01-2025A torto o a Regione
- 27-01-2025Tribunale alla carbonara
- 27-01-2023Giovedì Santo
- 27-01-2023Orario di chiusura
- 27-01-2022Parole Parole
- 27-01-2022La carica dei 500
- 27-01-2021Oggi facciamo le divisioni
- 27-01-2020C'era una volta in Veneto
- 27-01-2019Sgarbi Canoviani
- 27-01-2018Abbi tura di te
- 27-01-2018Morte da cani
- 27-01-2017Urban Students
- 27-01-2017Girano le pale
- 27-01-2015Voto a perdere
- 27-01-2014Correzione con beffa
- 27-01-2014Banche in Comune
- 27-01-2014Forza Nuova in corteo a Bassano
- 27-01-2013La lezione di Rommel
- 27-01-2013Lorenzato: “Alcuni dei “Padroni del Veneto” abitano a Romano”
- 27-01-2012L'ultima Adunata
- 27-01-2012ZTL. Cimatti: “Nessuno può vantare diritti di veto”
- 27-01-2012I parcheggi danno i numeri
- 27-01-2012Rosà: prime manovre elettorali
- 27-01-2012Plastica o secco? Questo è il dilemma
- 27-01-2011Donazzan: “Battisti, non invierò nessuna lettera alle scuole”
- 27-01-2011Magro, ma non abbastanza
- 27-01-2011Discariche ad acqua aperta
- 27-01-2011La mia Africa
- 27-01-2010Torri di Portoghesi: lettera aperta di Cimatti
- 27-01-2009Bassano celebra il giorno della memoria
- 27-01-2009Torri di Portoghesi: presentato il ricorso al Tar
Redattori
Più visti
Attualità
22-01-2026
L'ombra dell' "aereo dell'apocalisse" su Bassano: la rotta conferma il passaggio
Visto 9.261 volte
Politica
24-01-2026
‘è IL MOMENTO’: Gianfranco Cipresso alla guida del nuovo direttivo
Visto 8.201 volte
Attualità
24-01-2026
Chatbot e cittadini: istruzioni per l’uso al Palazzo del Doglione
Visto 7.759 volte
Attualità
24-01-2026
Da febbraio, attesi in Libreria AperiLibro e il Club Bassanese
Visto 7.693 volte
Ambiente
20-01-2026
L'aurora boreale accende i cieli del Bassanese: spettacolo a Rubbio
Visto 4.338 volte
Attualità
16-01-2026
Il 'The Times' incorona il Veneto: siamo noi la regione da visitare (impalcature comprese)
Visto 17.479 volte
Attualità
16-01-2026
La Fiamma Olimpica a Bassano: mercoledì 21 il passaggio sul Ponte Vecchio
Visto 14.060 volte
Geopolitica
05-01-2026
La Danimarca acquista missili dagli Stati Uniti nonostante le pretese di Trump sulla Groenlandia
Visto 11.658 volte
Geopolitica
29-12-2025
Pyongyang potenzia le operazioni di pirateria informatica legate alle criptovalute
Visto 9.490 volte
Politica
12-01-2026
«Narrazioni da romanzo e visibilità personale»: esplode il caso Polizia Locale
Visto 9.487 volte

Laura Vicenzi
Luigi Marcadella
Don Andrea Guglielmi
Dario Vanin
Elvio Rotondo
Marco Polo
Veronica Bizzotto
Vincenzo Pittureri